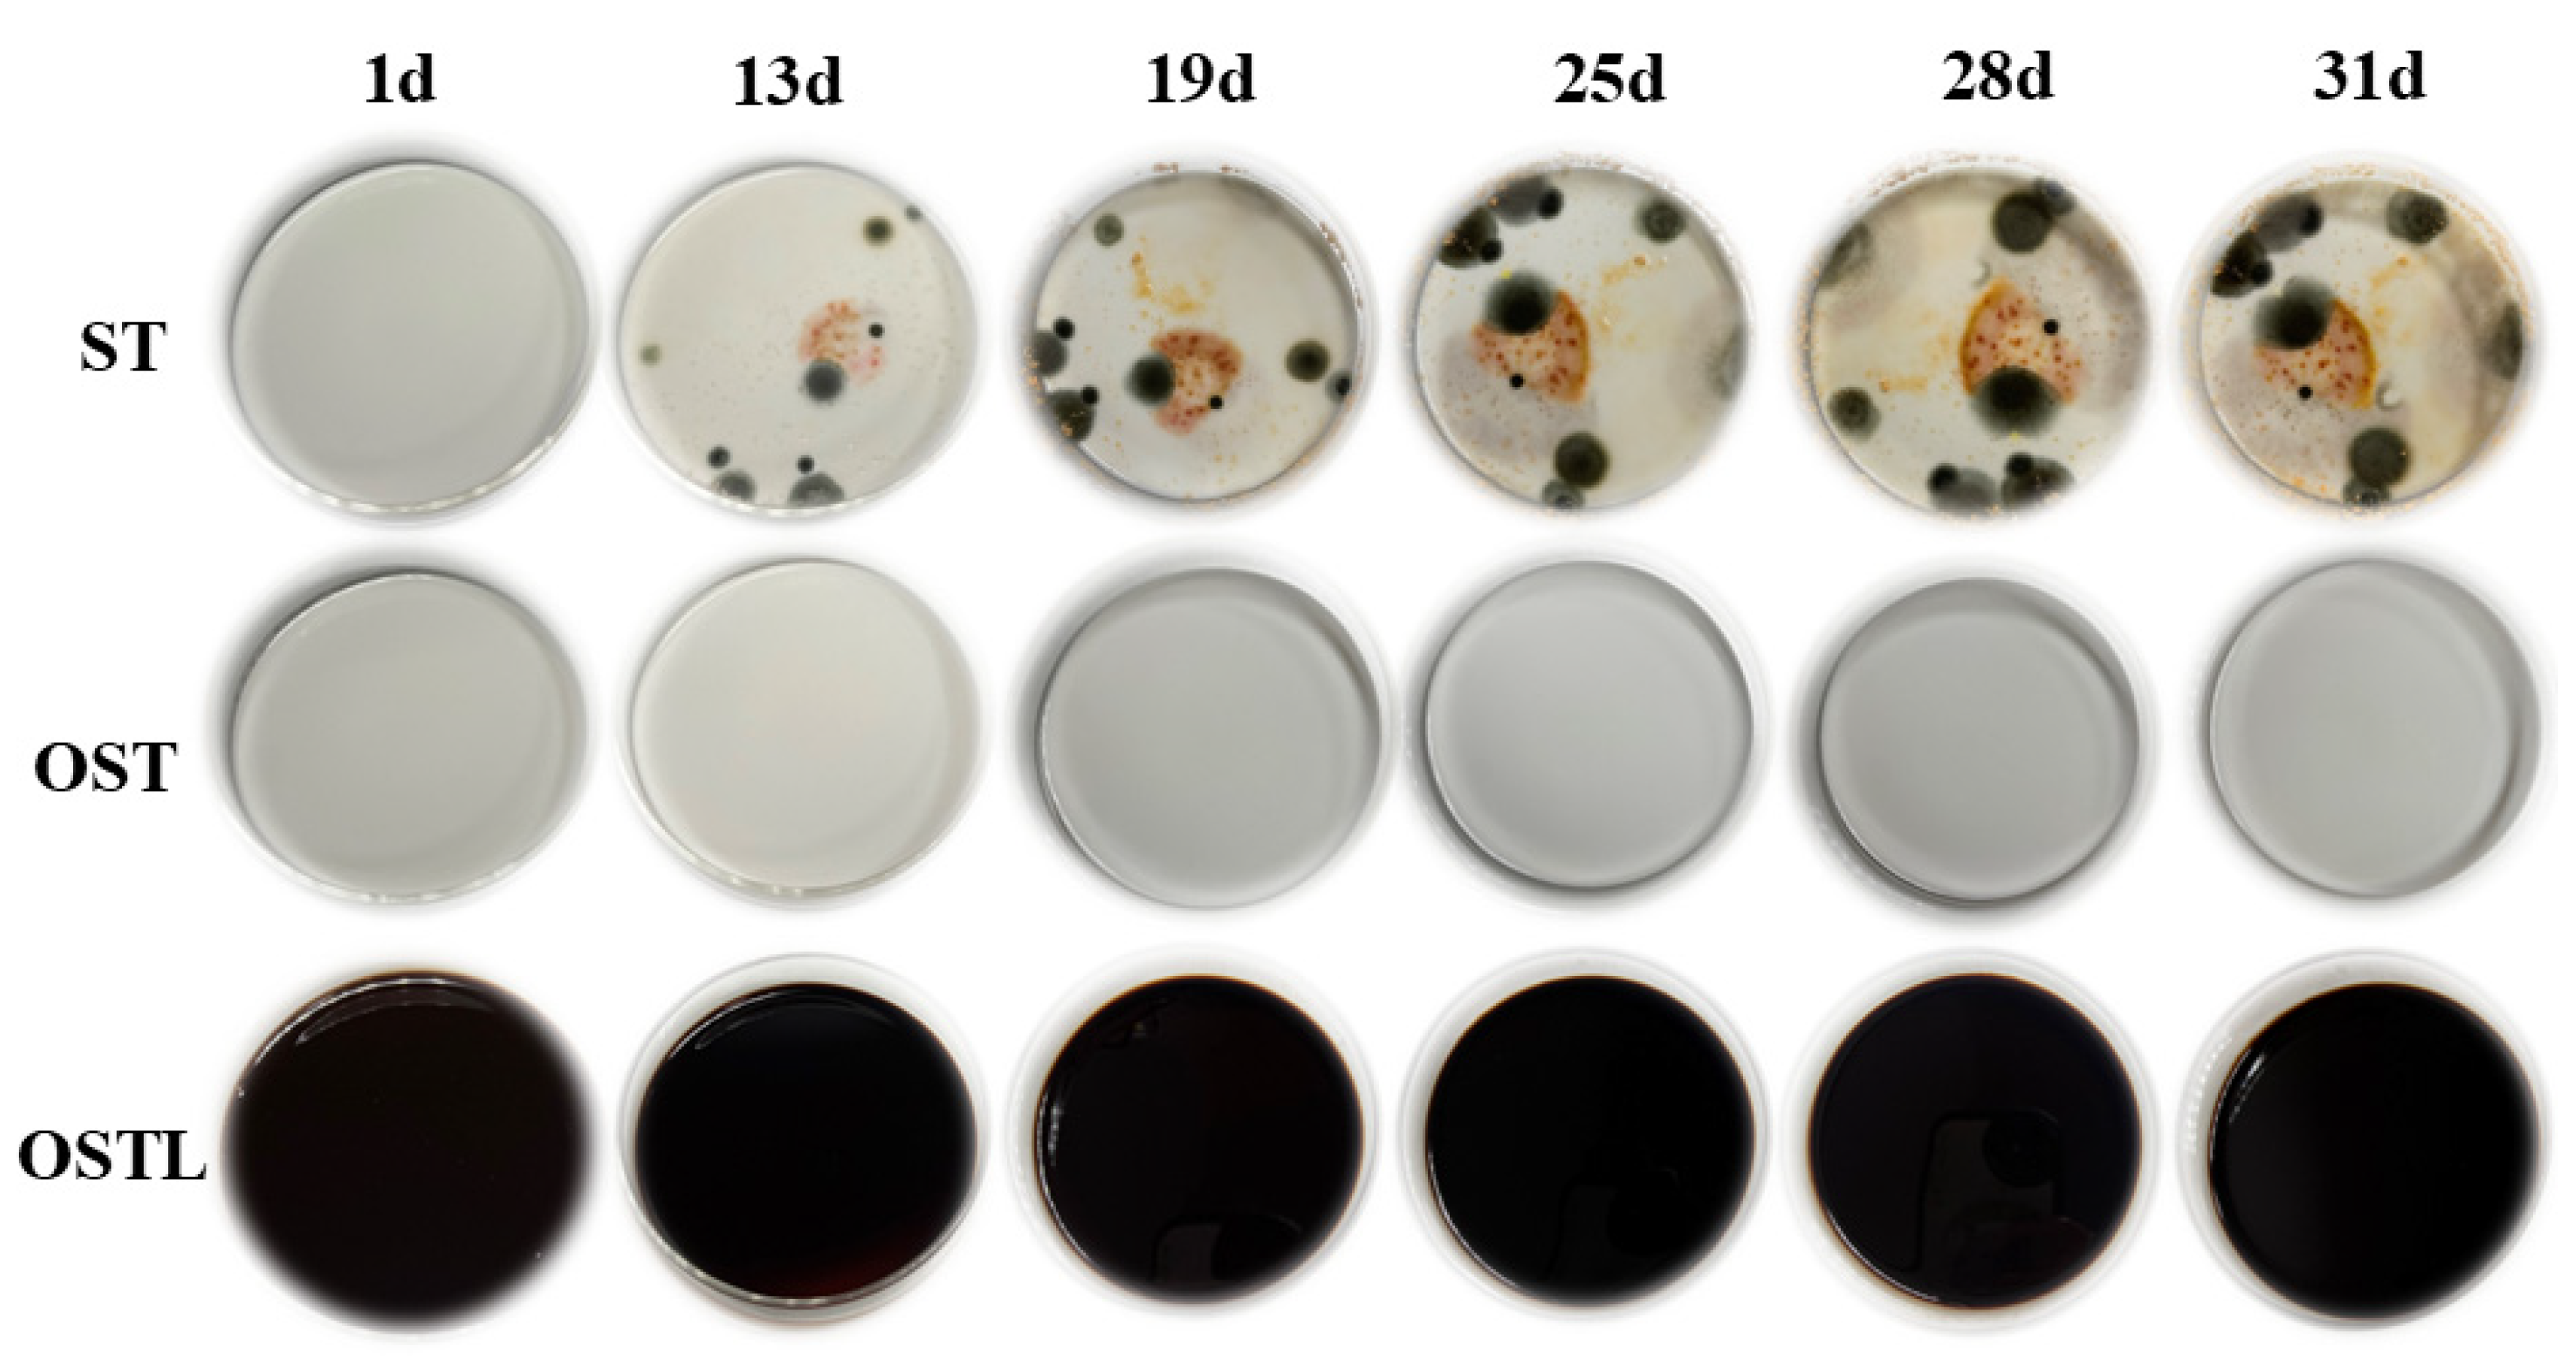
Polymers 17 01545 g008

Characterization of Water-Resistant Adhesive Prepared by Cross-Linking Reaction of Oxidized Starch with Lignin
Abstract
1. Introduction
2. Materials and Method
2.1. Materials
2.2. Preparation of Biodegradable Aldehyde via Oxidation of Starch
2.3. Preparation of OSTL Adhesive
2.4. Fourier Transform Infrared (FT-IR) Spectroscopy Investigation
2.5. Proton Nuclear Magnetic Resonance (1H-NMR) Investigation
2.6. XPS Investigation
2.7. Evaluation of Three-Layer Plywood Samples
2.8. Estimation of the Hydrolysis Residue Weight of the Cured Adhesive
2.9. Antifungal Performance of the Adhesive
2.10. Differential Scanning Calorimetry (DSC) Investigation
2.11. Dynamic Mechanical Analysis (DMA) Investigation
2.12. Thermogravimetric Analysis (TGA)
3. Results and Discussion
3.1. Structural Analysis of OST
3.2. Structural Characterization of the OSTL Adhesive
3.3. Evaluation of the Antifungal Performance of Adhesives
3.4. The Effect of Different Oxidation Times on the Performance of OSTL Adhesives
3.5. Effect of Oxidizing Agent Dose on the Performance of OSTL Adhesives
3.6. The Impact of Different Mass Ratios of ST-to-L on the Performance of OSTL Adhesives
3.7. Effect of Different Hot-Pressing Temperatures on the Performance of OSTL Adhesives
4. Conclusions
Author Contributions
Funding
Data Availability Statement
Acknowledgments
Conflicts of Interest
References
- Li, R.J.; Gutierrez, J.; Chung, Y.-L.; Frank, C.W.; Billington, S.L.; Sattely, E.S. A Lignin-Epoxy Resin Derived from Biomass as an Alternative to Formaldehyde-Based Wood Adhesives. Green Chem. R. Soc. Chem. 2018, 20, 1459–1466. [Google Scholar] [CrossRef]
- Shi, X.; Gao, S.; Jin, C.; Zhang, D.; Lai, C.; Wang, C.; Chu, F.; Ragauskas, A.J.; Li, M. A Facile Strategy to Fabricate a Lignin-Based Thermoset Alternative to Formaldehyde-Based Wood Adhesives. Green Chem. R. Soc. Chem. 2023, 25, 5907–5915. [Google Scholar] [CrossRef]
- Balk, M.; Sofia, P.; Neffe, A.T.; Tirelli, N. Lignin, the lignification process, and advanced, lignin-based materials. Int. J. Mol. Sci. 2023, 24, 11668. [Google Scholar] [CrossRef]
- Rath, S.; Pradhan, D.; Du, H.; Mohapatra, S.; Thatoi, H. Transforming lignin into value-added products: Perspectives on lignin chemistry, lignin-based biocomposites, and pathways for augmenting ligninolytic enzyme production. Adv. Compos. Hybrid Mater. 2024, 7, 27. [Google Scholar] [CrossRef]
- Sarkar, S.; Adhikari, B. Lignin-Modified Phenolic Resin: Synthesis Optimization, Adhesive Strength, and Thermal Stability. J. Adhes. Sci. Technol. 2000, 14, 1179–1193. [Google Scholar] [CrossRef]
- Nonaka, Y.; Tomita, B.; Hatano, Y. Synthesis of Lignin/Epoxy Resins in Aqueous Systems and Their Properties. Holzforschung 1997, 51, 183–187. [Google Scholar] [CrossRef]
- El Mansouri, N.; Pizzi, A.; Salvado, J. Lignin-Based Polycondensation Resins for Wood Adhesives. J. Appl. Polym. Sci. 2010, 103, 1690–1699. [Google Scholar] [CrossRef]
- Mansouri, H.R.; Pizzi, A. Urea–Formaldehyde–Propionaldehyde Physical Gelation Resins for Improved Swelling in Water. J. Appl. Polym. Sci. 2006, 102, 5131–5136. [Google Scholar] [CrossRef]
- Wu, Z.; Xi, X.; Lei, H.; Du, G. Soy-Based Adhesive Cross-Linked by Phenol-Formaldehyde-Glutaraldehyde. Polymers 2017, 9, 169. [Google Scholar] [CrossRef]
- El-Mansouri, N.; Pizzi, A.; Salvadó, J. Lignin-based wood panel adhesives without formaldehyde. Holz. Roh. Werkst. 2007, 65, 65–70. [Google Scholar] [CrossRef]
- Van Nieuwenhove, I.; Renders, T.; Lauwaert, J.; De Roo, T.; De Clercq, J.; Verberckmoes, A. Biobased Resins Using Lignin and Glyoxal. ACS Sustain. Chem. Eng. 2020, 8, 18789–18809. [Google Scholar] [CrossRef]
- Hussin, M.H.; Aziz, A.A.; Iqbal, A.; Ibrahim, M.N.M.; Abd Latif, N.H. Development and Characterization Novel Bio-Adhesive for Wood Using Kenaf Core (Hibiscus Cannabinus) Lignin and Glyoxal. Int. J. Biol. Macromol. 2019, 122, 713–722. [Google Scholar] [CrossRef] [PubMed]
- Huzyan, H.I.; Abdul Aziz, A.; Hussin, M.H. Ecofriendly Wood Adhesives from Date Palm Fronds Lignin for Plywood. BioResources 2021, 16, 4106–4125. [Google Scholar] [CrossRef]
- Chupin, L.; Charrier, B.; Pizzi, A.; Perdomo, A.; Bouhtoury, F.C.-E. Study of Thermal Durability Properties of Tannin-Lignosulfonate Adhesives. J. Therm. Anal. Calorim. 2015, 119, 1577–1585. [Google Scholar] [CrossRef]
- Zhang, Y.; Yuan, Z.; Mahmood, N.; Huang, S.; Xu, C. Sustainable Bio-Phenol-Hydroxymethylfurfural Resins Using Phenolated de-Polymerized Hydrolysis Lignin and Their Application in Bio-Composites. Ind. Crops Prod. 2016, 79, 84–90. [Google Scholar] [CrossRef]
- Dongre, P.; Driscoll, M.; Amidon, T.; Bujanovic, B. Lignin-Furfural Based Adhesives. Energies 2015, 8, 7897–7914. [Google Scholar] [CrossRef]
- Fadlallah, S.; Roy, P.S.; Garnier, G.; Saito, K.; Allais, F. Are Lignin-Derived Monomers and Polymers Truly Sustainable? An in-Depth Green Metrics Calculations Approach. Green Chem. 2021, 23, 1495–1535. [Google Scholar] [CrossRef]
- Diaz-Baca, J.A.; Fatehi, P. Production and Characterization of Starch-Lignin Based Materials: A Review. Biotechnol. Adv. 2024, 70, 108281. [Google Scholar] [CrossRef]
- Ferreira-Filipe, D.A.; Paço, A.; Duarte, A.C.; Rocha-Santos, T.; Patrício Silva, A.L. Are Biobased Plastics Green Alternatives?—A Critical Review. Int. J. Environ. Res. Public Health 2021, 18, 7729. [Google Scholar] [CrossRef]
- Weiss, M.; Haufe, J.; Carus, M.; Brandão, M.; Bringezu, S.; Hermann, B.; Patel, M.K. A Review of the Environmental Impacts of Biobased Materials. J. Ind. Ecol. 2012, 16, S169–S181. [Google Scholar] [CrossRef]
- Amagliani, L.; O’regan, J.; Kelly, A.L.; O’mahony, J.A. Chemistry, Structure, Functionality and Applications of Rice Starch. J. Cereal Sci. 2016, 70, 291–300. [Google Scholar] [CrossRef]
- Luchese, C.L.; Benelli, P.; Spada, J.C.; Tessaro, I.C. Impact of the Starch Source on the Physicochemical Properties and Biodegradability of Different Starch-based Films. J. Appl. Polym. Sci. 2018, 135, 46564. [Google Scholar] [CrossRef]
- Van Hung, P.; Maeda, T.; Morita, N. Waxy and High-Amylose Wheat Starches and Flours—Characteristics, Functionality and Application. Trends Food Sci. Technol. 2006, 17, 448–456. [Google Scholar] [CrossRef]
- Kristiansen, K.A.; Potthast, A.; Christensen, B.E. Periodate Oxidation of Polysaccharides for Modification of Chemical and Physical Properties. Carbohydr. Res. 2010, 345, 1264–1271. [Google Scholar] [CrossRef] [PubMed]
- Vanier, N.L.; El Halal, S.L.M.; Dias, A.R.G.; da Rosa Zavareze, E. Molecular Structure, Functionality and Applications of Oxidized Starches: A Review. J. Food Chem. 2017, 221, 1546–1559. [Google Scholar] [CrossRef]
- Apriyanto, A.; Compart, J.; Fettke, J. A Review of Starch, a Unique Biopolymer—Structure, Metabolism and in Planta Modifications. Plant Sci. 2022, 318, 111223. [Google Scholar] [CrossRef]
- Zhao, Z.Q.; Ouyang, X.P. Effect of Oxidation on the Structures and Properties of Lignin. Adv. Mater. Res. 2012, 550–553, 1208–1213. [Google Scholar] [CrossRef]
- GB/T 17657-2022; Test methods of evaluating the properties of wood-based panels and surface decorated wood-based panels. National Forestry and Grassland Administration: Beijing, China, 2022.
- Shao, J.; Li, X.; Liu, T.; Chen, S.; Gong, S.; Cao, J.; Zhou, W.; Li, C.; Li, J. Multiple Function Hyperbranched Polysiloxane Nanoclusters for Controlling a Cross-Linking Structure to Convert Soy Meal into a Strong, Tough, and Multifunctional Adhesive. ACS Sustain. Chem. Eng. 2024, 12, 3966–3976. [Google Scholar] [CrossRef]
- Lin, Q.; Pan, J.; Lin, Q.; Liu, Q. Microwave Synthesis and Adsorption Performance of a Novel Crosslinked Starch Microsphere. J. Hazard. Mater. 2013, 263, 517–524. [Google Scholar] [CrossRef]
- Li, J.; Du, M.; Din, Z.U.; Xu, P.; Chen, L.; Chen, X.; Wang, Y.; Cao, Y.; Zhuang, K.; Cai, J.; et al. Multi-Scale Structure Characterization of Ozone Oxidized Waxy Rice Starch. Carbohydr. Polym. 2023, 307, 120624. [Google Scholar] [CrossRef]
- Serrero, A.; Trombotto, S.; Cassagnau, P.; Bayon, Y.; Gravagna, P.; Montanari, S.; David, L. Polysaccharide Gels Based on Chitosan and Modified Starch: Structural Characterization and Linear Viscoelastic Behavior. Biomacromolecules 2010, 11, 1534–1543. [Google Scholar] [CrossRef] [PubMed]
- Lyu, F.; van der Poel, A.F.B.; Hendriks, W.H.; Thomas, M. Particle Size Distribution of Hammer-Milled Maize and Soybean Meal, Its Nutrient Composition and in Vitro Digestion Characteristics. Anim. Feed. Sci. Technol. 2021, 281, 115095. [Google Scholar] [CrossRef]
- Song, S.; Gao, P.; Sun, L.; Kang, D.; Kongsted, J.; Poongavanam, V.; Zhan, P.; Liu, X. Recent Developments in the Medicinal Chemistry of Single Boron Atom-Containing Compounds. Acta Pharm. Sin. B 2021, 11, 3035–3059. [Google Scholar] [CrossRef] [PubMed]
- Haghighi, F.H.; Mercurio, M.; Cerra, S.; Salamone, T.A.; Bianymotlagh, R.; Palocci, C.; Spica, V.R.; Fratoddi, I. Surface Modification of TiO 2 Nanoparticles with Organic Molecules and Their Biological Applications. J. Mater. Chem. B 2023, 11, 2334–2366. [Google Scholar] [CrossRef]
- Nguyen, N.Y.; Luong, H.V.T.; Pham, D.T.; Cao, L.N.H.; Nguyen, T.T.; Le, T.P. Drug-loaded Fe3O4/lignin nanoparticles to treat bacterial infections. Int. J. Biol. Macromol. 2025, 289, 138868. [Google Scholar] [CrossRef]
- Chen, S.; Shi, S.Q.; Zhou, W.; Li, J. Developments in bio-based soy protein adhesives: A review. Macromol. Mater. Eng. 2022, 307, 2200277. [Google Scholar] [CrossRef]
- Cao, L.; Pizzi, A.; Zhang, Q.; Tian, H.; Lei, H.; Xi, X.; Du, G. Preparation and Characterization of a Novel Environment-Friendly Urea-Glyoxal Resin of Improved Bonding Performance. Eur. Polym. J. 2022, 162, 110915. [Google Scholar] [CrossRef]
- Xu, Y.; Xu, Y.; Han, Y.; Chen, M.; Zhang, W.; Gao, Q.; Li, J. The Effect of Enzymolysis on Performance of Soy Protein-Based Adhesive. Molecules 2018, 23, 2752. [Google Scholar] [CrossRef]

| Name | Peak | FWHM (eV) | Area (P) CPS. eV | Atomic (%) |
|---|---|---|---|---|
| C-C | 284.80 | 1.21 | 46,384.29 | 35.70 |
| C-O | 286.52 | 1.51 | 69,450.80 | 53.45 |
| C-O-C | 288.12 | 1.84 | 14,109.65 | 10.86 |
| Name | Peak | FWHM (eV) | Area (P) CPS. eV | Atomic (%) |
|---|---|---|---|---|
| C-C | 284.80 | 1.34 | 23,135.67 | 16.07 |
| C-O | 286.35 | 1.38 | 98,516.11 | 68.44 |
| C=O | 287.76 | 1.21 | 16,834.70 | 11.70 |
| O-C=O | 288.60 | 1.48 | 5449.34 | 3.79 |
| Name | Peak | FWHM (eV) | Area (P) CPS. eV | Atomic (%) |
|---|---|---|---|---|
| C-O | 532.80 | 1.85 | 212,974.74 | 93.92 |
| C=O | 531.30 | 1.29 | 13,710.86 | 6.05 |
| O-C=O | 534.90 | 1.30 | 86.48 | 0.04 |
| Name | Peak | FWHM (eV) | Area (P) CPS. eV | Atomic (%) |
|---|---|---|---|---|
| C-O | 532.70 | 2.48 | 158,164.89 | 99.62 |
| C=O | 529.00 | 0.54 | 225.13 | 0.14 |
| O-C=O | 534.82 | 0.54 | 373.98 | 0.24 |
| Time/h | Starting Temperature/°C | Maximum Exothermic Peak/°C | Termination Temperature/°C | Enthalpy/(J·g−1) |
|---|---|---|---|---|
| 3 | 162.0 | 166.8 | 174.2 | 951.7 |
| 6 | 128.1 | 137.0 | 145.1 | 951.4 |
| 9 | 169.7 | 176.9 | 184.5 | 1156.0 |
| 12 | 159.4 | 165.4 | 172.2 | 1024.0 |
| Additions/% | Starting Temperature/°C | Maximum Exothermic Peak/°C | Termination Temperature/°C | Enthalpy/(J·g−1) |
|---|---|---|---|---|
| 9 | 142.8 | 148.1 | 153.5 | 666 |
| 11 | 144.0 | 154.8 | 162.1 | 997.4 |
| 13 | 128.1 | 137.0 | 145.1 | 951.4 |
| 15 | 125.5 | 141.1 | 150.1 | 814.2 |
| 17 | 126.3 | 140.5 | 149.8 | 779.8 |
| ST | Starting Temperature/°C | Maximum Exothermic Peak/°C | Termination Temperature/°C | Enthalpy/(J·g−1) |
|---|---|---|---|---|
| 0.6 | 110.5 | 127.5 | 137.9 | 689.2 |
| 0.8 | 128.1 | 137.0 | 145.1 | 988.2 |
| 1.0 | 128.3 | 137.8 | 144.9 | 970.2 |
| 1.2 | 128.7 | 138.1 | 145.1 | 978.0 |
Disclaimer/Publisher’s Note: The statements, opinions and data contained in all publications are solely those of the individual author(s) and contributor(s) and not of MDPI and/or the editor(s). MDPI and/or the editor(s) disclaim responsibility for any injury to people or property resulting from any ideas, methods, instructions or products referred to in the content. |
© 2025 by the authors. Licensee MDPI, Basel, Switzerland. This article is an open access article distributed under the terms and conditions of the Creative Commons Attribution (CC BY) license (https://creativecommons.org/licenses/by/4.0/).
Share and Cite
Liu, C.; Lin, H.; Zhang, S.; Essawy, H.; Wang, H.; Wu, L.; Chen, X.; Zhou, X.; Papadopoulos, A.N.; Pizzi, A.; et al. Characterization of Water-Resistant Adhesive Prepared by Cross-Linking Reaction of Oxidized Starch with Lignin. Polymers 2025, 17, 1545. https://doi.org/10.3390/polym17111545
Liu C, Lin H, Zhang S, Essawy H, Wang H, Wu L, Chen X, Zhou X, Papadopoulos AN, Pizzi A, et al. Characterization of Water-Resistant Adhesive Prepared by Cross-Linking Reaction of Oxidized Starch with Lignin. Polymers. 2025; 17(11):1545. https://doi.org/10.3390/polym17111545
Chicago/Turabian StyleLiu, Chengyuan, Huali Lin, Shichao Zhang, Hisham Essawy, Hongyan Wang, Longxu Wu, Xinyi Chen, Xiaojian Zhou, Antonios N. Papadopoulos, Antonio Pizzi, and et al. 2025. "Characterization of Water-Resistant Adhesive Prepared by Cross-Linking Reaction of Oxidized Starch with Lignin" Polymers 17, no. 11: 1545. https://doi.org/10.3390/polym17111545
APA StyleLiu, C., Lin, H., Zhang, S., Essawy, H., Wang, H., Wu, L., Chen, X., Zhou, X., Papadopoulos, A. N., Pizzi, A., & Cao, M. (2025). Characterization of Water-Resistant Adhesive Prepared by Cross-Linking Reaction of Oxidized Starch with Lignin. Polymers, 17(11), 1545. https://doi.org/10.3390/polym17111545

